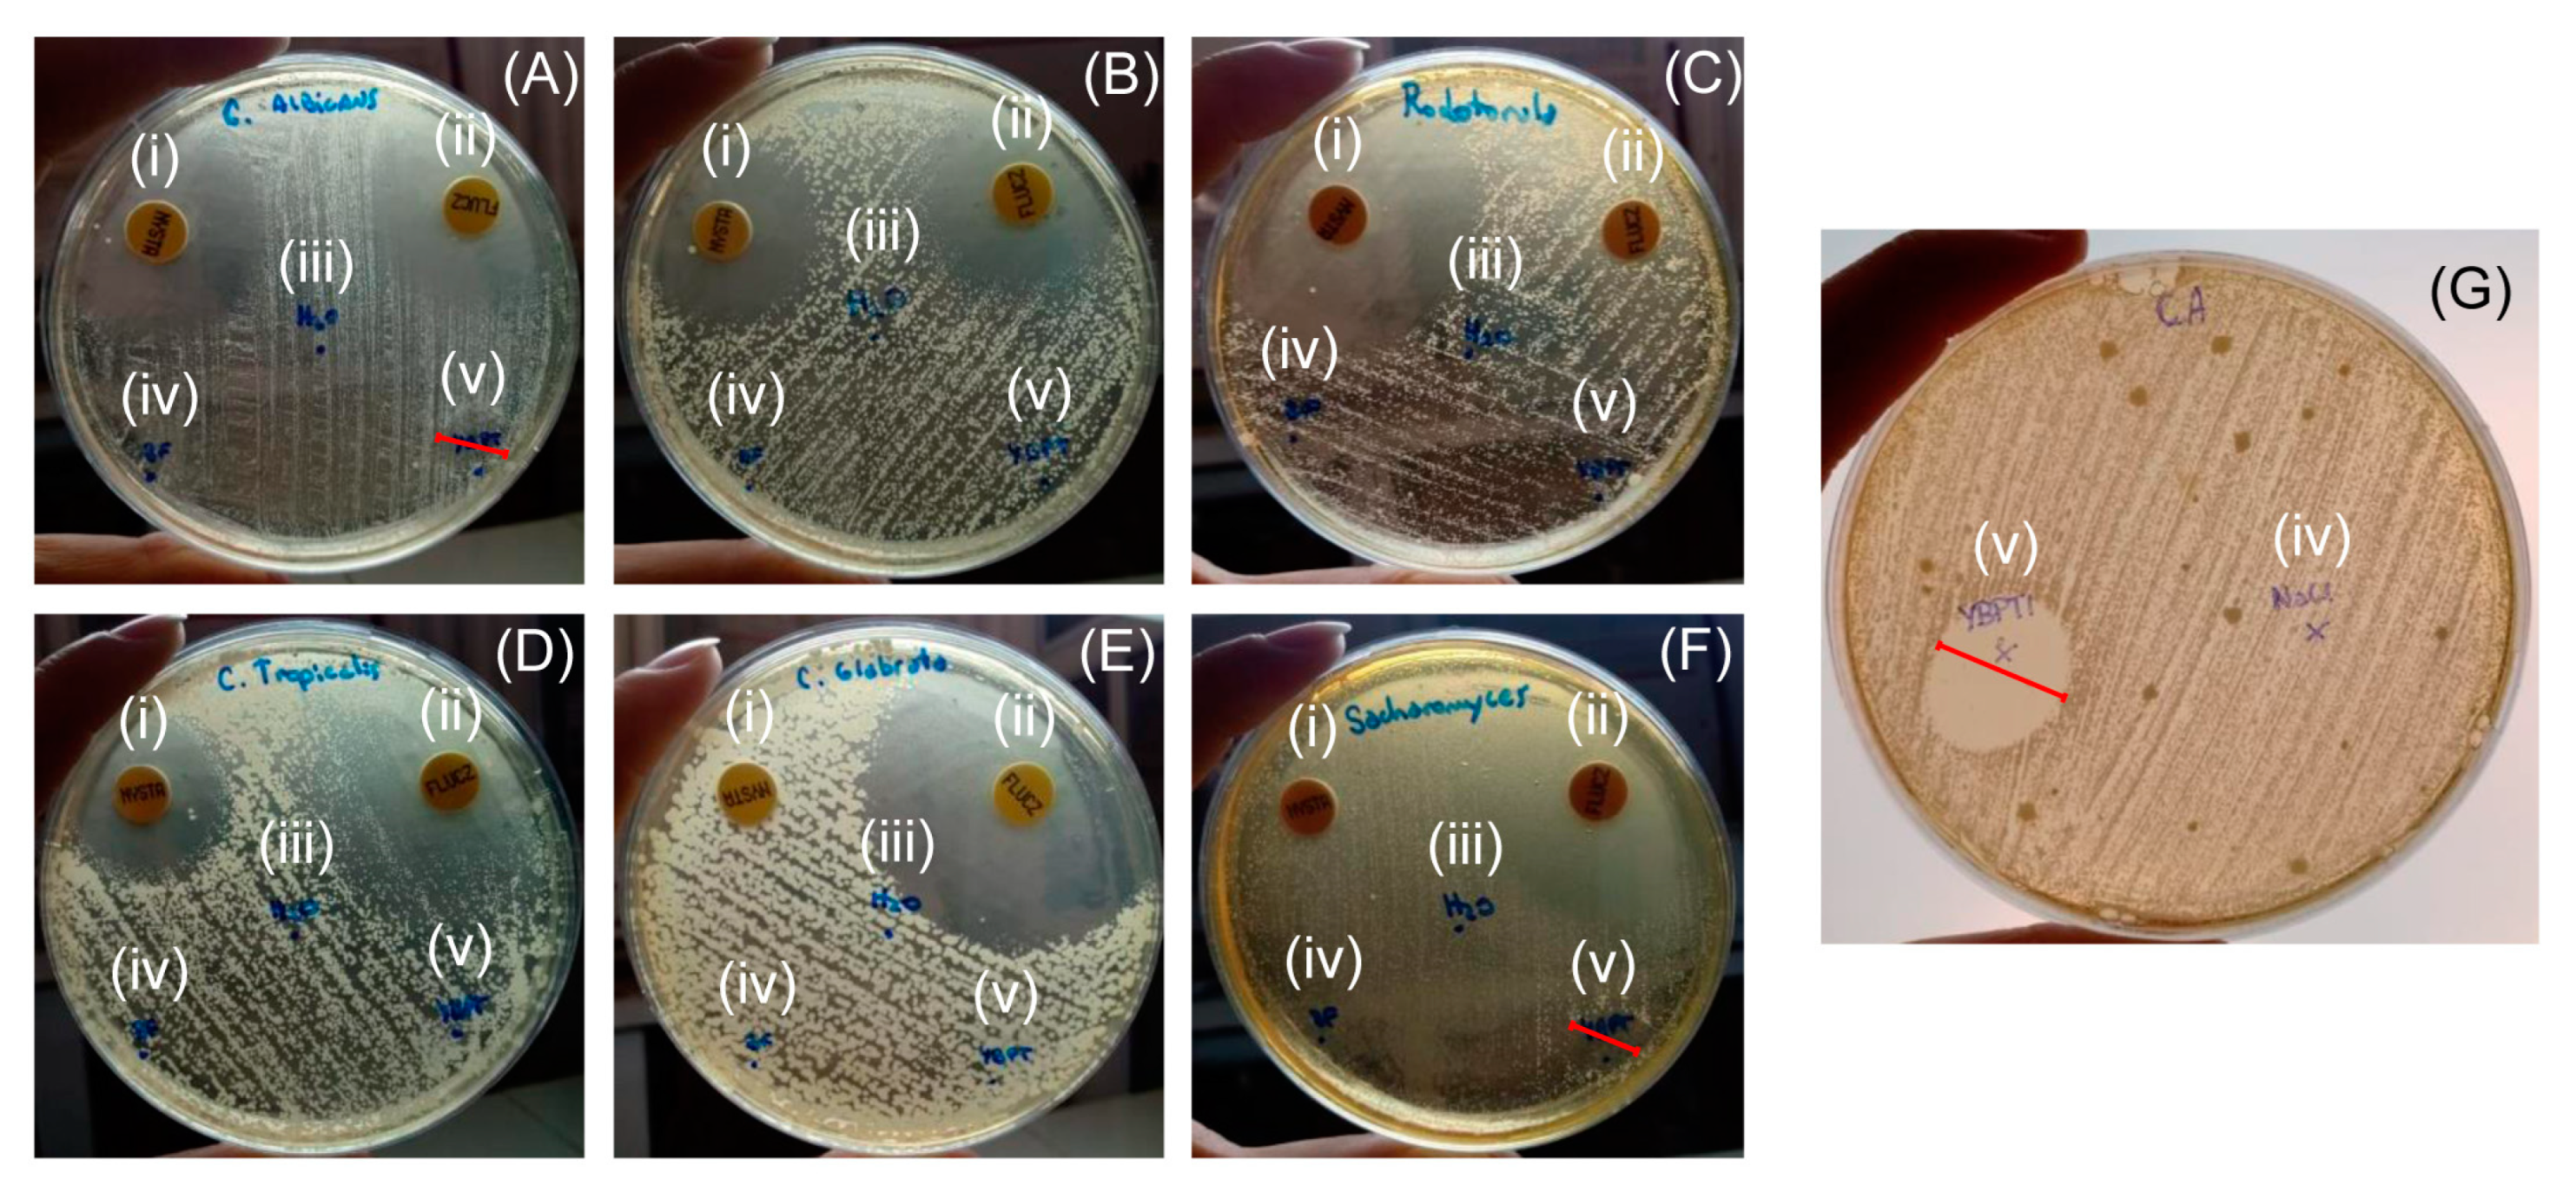

A Multifunctional Trypsin Protease Inhibitor from Yellow Bell Pepper Seeds: Uncovering Its Dual Antifungal and Hypoglycemic Properties
Abstract
1. Introduction
2. Materials and Methods
2.1. Materials
2.2. Cell Lines and Pathogenic Microbial Strains
2.3. Crude Extract Preparation
2.4. Trypsin Inhibition Measurements
2.5. Heat Treatment and Affinity Chromatography Purification
2.6. Biochemical Characterization of the Inhibitor
2.6.1. Inhibitory Assays and Ki Determination
2.6.2. YBPTI Stability Studies
2.7. Biological Assays
2.7.1. Antimicrobial Activity against Pathogenic Bacterial and Fungal Strains
2.7.2. Antimicrobial Activity against Pathogenic Candida Albicans
2.7.3. Plasma Membrane Permeabilization Experiments
2.7.4. Hypoglycemic Activity
2.7.5. Cytotoxicity Assays
3. Results and Discussion
3.1. Isolation and Purification of YBPTI
3.2. Inhibition Kinetics and Physicochemical Properties of YBPTI
3.3. Antifungal Activity of YBPTI
3.4. Hypoglycemic Activity of YBPTI
3.5. Cytotoxicity of YBPTI against HeLa Cells
4. Conclusions
Supplementary Materials
Author Contributions
Funding
Institutional Review Board Statement
Informed Consent Statement
Data Availability Statement
Conflicts of Interest
References
- Kainz, K.; Bauer, M.A.; Madeo, F.; Carmona-Gutierrez, D. Fungal Infections in Humans: The Silent Crisis. Microb. Cell 2020, 7, 143–145. [Google Scholar] [CrossRef] [PubMed]
- Lee, Y.; Puumala, E.; Robbins, N.; Cowen, L.E. Antifungal Drug Resistance: Molecular Mechanisms in Candida Albicans and Beyond. Chem. Rev. 2021, 121, 3390–3411. [Google Scholar] [CrossRef]
- Burchacka, E.; Pięta, P.; Łupicka-Słowik, A. Recent Advances in Fungal Serine Protease Inhibitors. Biomed. Pharmacother. 2022, 146, 112523. [Google Scholar] [CrossRef] [PubMed]
- Otvos, R.A.; Still, K.B.M.; Somsen, G.W.; Smit, A.B.; Kool, J. Drug Discovery on Natural Products: From Ion Channels to NAChRs, from Nature to Libraries, from Analytics to Assays. SLAS DISCOVERY Adv. Life Sci. RD 2019, 24, 362–385. [Google Scholar] [CrossRef]
- Cotabarren, J.; Lufrano, D.; Parisi, M.G.; Obregón, W.D. Biotechnological, Biomedical, and Agronomical Applications of Plant Protease Inhibitors with High Stability: A Systematic Review. Plant Sci. 2020, 288, 110398. [Google Scholar] [CrossRef]
- Cisneros, J.S.; Cotabarren, J.; Parisi, M.G.; Vasconcelos, M.W.; Obregón, W.D. Purification and Characterization of a Novel Trypsin Inhibitor from Solanum Tuberosum Subsp. Andigenum Var. Overa: Study of the Expression Levels and Preliminary Evaluation of Its Antimicrobial Activity. Int. J. Biol. Macromol. 2020, 158, 1279–1287. [Google Scholar] [CrossRef] [PubMed]
- Cotabarren, J.; Claver, S.; Payrol, J.A.; Garcia-pardo, J.; Obregón, W.D. Purification and Characterization of a Novel Thermostable Pa- Pain Inhibitor from Moringa Oleifera with Antimicrobial and anticoagulant Properties. Pharmaceutics 2021, 13, 512. [Google Scholar] [CrossRef] [PubMed]
- Gutierrez-Gongora, D.; Geddes-Mcalister, J. From Naturally-Sourced Protease Inhibitors to New Treatments for Fungal Infections. J. Fungi 2021, 7, 1016. [Google Scholar] [CrossRef]
- Shamsi, T.N.; Parveen, R.; Fatima, S. Characterization, Biomedical and Agricultural Applications of Protease Inhibitors: A Review. Int. J. Biol. Macromol. 2016, 91, 1120–1133. [Google Scholar] [CrossRef]
- Kim, J.Y.; Park, S.C.; Hwang, I.; Cheong, H.; Nah, J.W.; Hahm, K.S.; Park, Y. Protease Inhibitors from Plants with Antimicrobial Activity. Int. J. Mol. Sci. 2009, 10, 2860–2872. [Google Scholar] [CrossRef]
- Cotabarren, J.; Tellechea, M.E.; Avilés, F.X.; Lorenzo Rivera, J.; Obregón, W.D. Biochemical Characterization of the YBPCI Miniprotein, the First Carboxypeptidase Inhibitor Isolated from Yellow Bell Pepper (Capsicum Annuum L). A Novel Contribution to the Knowledge of Miniproteins Stability. Protein Expr. Purif. 2018, 144, 55–61. [Google Scholar] [CrossRef]
- Cotabarren, J.; Broitman, D.J.; Quiroga, E.; Obregón, W.D. GdTI, the First Thermostable Trypsin Inhibitor from Geoffroea Decorticans Seeds. A Novel Natural Drug with Potential Application in Biomedicine. Int. J. Biol. Macromol. 2020, 148, 869–879. [Google Scholar] [CrossRef] [PubMed]
- Bradford, M.M. A Rapid and Sensitive Method for the Quantitation of Microgram Quantities of Protein Utilizing the Principle of Protein-Dye Binding. Anal. Biochem. 1976, 72, 248–254. [Google Scholar] [CrossRef]
- Erlanger, B.F.; Kokowsky, N.; Cohen, W. The Preparation and Properties of Two New Chromogenic Substrates of Trypsin. Arch. Biochem. Biophys. 1961, 95, 271–278. [Google Scholar] [CrossRef]
- Obregón, W.D.; Ghiano, N.; Tellechea, M.; Cisneros, J.S.; Lazza, C.M.; López, L.M.I.; Avilés, F.X. Detection and Characterisation of a New Metallocarboxypeptidase Inhibitor from Solanum Tuberosum Cv. Desirèe Using Proteomic Techniques. Food Chem. 2012, 133, 1163–1168. [Google Scholar] [CrossRef]
- Tellechea, M.; Garcia-Pardo, J.; Cotabarren, J.; Lufrano, D.; Bakas, L.; Avil?s, F.; Obregon, W.; Lorenzo, J.; Tanco, S. Microplate Assay to Study Carboxypeptidase A Inhibition in Andean Potatoes. Bio-Protocol 2016, 6, e2032. [Google Scholar] [CrossRef]
- Bauer, A.W.; Kirby, W.M.; Sherris, J.C.; Turck, M. Antibiotic Susceptibility Testing by a Standardized Single Disk Method. Am. J. Clin. Pathol. 1966, 45, 493–496. [Google Scholar] [CrossRef]
- Thevissen, K.; Terras, F.R.G.; Broekaert, W.F. Permeabilization of Fungal Membranes by Plant Defensins Inhibits Fungal Growth. Appl. Environ. Microbiol. 1999, 65, 5451–5458. [Google Scholar] [CrossRef]
- Kim, Y.M.; Wang, M.H.; Rhee, H.I. A Novel α-Glucosidase Inhibitor from Pine Bark. Carbohydr. Res. 2004, 339, 715–717. [Google Scholar] [CrossRef]
- Mosmann, T. Rapid Colorimetric Assay for Cellular Growth and Survival: Application to Proliferation and Cytotoxicity Assays. J. Immunol. Methods 1983, 65, 55–63. [Google Scholar] [CrossRef]
- Twentyman, P.R.; Luscombe, M. A Study of Some Variables in a Tetrazolium Dye (MTT) Based Assay for Cell Growth and Chemosensitivity. Br. J. Cancer 1987, 56, 279–285. [Google Scholar] [CrossRef] [PubMed]
- Anaya-Esparza, L.M.; de la Mora, Z.V.; Vázquez-Paulino, O.; Ascencio, F.; Villarruel-López, A. Bell Peppers (Capsicum Annum L.) Losses and Wastes: Source for Food and Pharmaceutical Applications. Molecules 2021, 26, 5341. [Google Scholar] [CrossRef]
- Antcheva, N.; Pintar, A.; Patthy, A.; Simoncsits, A.; Barta, E.; Tchorbanov, B.; Pongor, S. Proteins of Circularly Permuted Sequence Present within the Same Organism: The Major Serine Proteinase Inhibitor from Capsicum Annuum Seeds. Protein Sci. 2001, 10, 2280–2290. [Google Scholar] [CrossRef] [PubMed]
- Ribeiro, S.F.F.; Silva, M.S.; Da Cunha, M.; Carvalho, A.O.; Dias, G.B.; Rabelo, G.; Mello, É.O.; Santa-Catarina, C.; Rodrigues, R.; Gomes, V.M. Capsicum Annuum L. trypsin Inhibitor as a Template Scaffold for New Drug Development against Pathogenic Yeast. Antonie van Leeuwenhoek. Int. J. Gen. Mol. Microbiol. 2012, 101, 657–670. [Google Scholar] [CrossRef]
- Ribeiro, S.F.F.; Fernandes, K.V.S.; Santos, I.S.; Taveira, G.B.; Carvalho, A.O.; Lopes, J.L.S.; Beltramini, L.M.; Rodrigues, R.; Vasconcelos, I.M.; Da Cunha, M.; et al. New Small Proteinase Inhibitors from Capsicum Annuum Seeds: Characterization, Stability, Spectroscopic Analysis and a CDNA Cloning. Biopolymers 2013, 100, 132–140. [Google Scholar] [CrossRef]
- Tamhane, V.A.; Chougule, N.P.; Giri, A.P.; Dixit, A.R.; Sainani, M.N.; Gupta, V.S. In Vivo and in Vitro Effect of Capsicum Annum Proteinase Inhibitors on Helicoverpa Armigera Gut Proteinases. Biochim. Biophys. Acta–Gen. Subj. 2005, 1722, 156–167. [Google Scholar] [CrossRef]
- Tanaka, A.S.; Andreotti, R.; Gomes, A.; Torquato, R.J.S.; Sampaio, M.U.; Sampaio, C.A.M. A Double Headed Serine Proteinase Inhibitor—Human Plasma Kallikrein and Elastase Inhibitor—from Boophilus Microplus Larvae. Immunopharmacology 1999, 45, 171–177. [Google Scholar] [CrossRef]
- Sasaki, S.D.; de Lima, C.A.; Lovato, D.V.; Juliano, M.A.; Torquato, R.J.S.; Tanaka, A.S. BmSI-7, a Novel Subtilisin Inhibitor from Boophilus Microplus, with Activity toward Pr1 Proteases from the Fungus Metarhizium Anisopliae. Exp. Parasitol. 2008, 118, 214–220. [Google Scholar] [CrossRef]
- Sampaio, C.A.; Oliva, M.L.; Tanaka, A.S.; Sampaio, M.U. Proteinase Inhibitors in Brazilian Leguminosae. Memórias Do Inst. Oswaldo Cruz 1991, 86, 207–209. [Google Scholar] [CrossRef]
- Aguirre, C.; Valdés-Rodríguez, S.; Mendoza-Hernández, G.; Rojo-Domínguez, A.; Blanco-Labra, A. A Novel 8.7 KDa Protease Inhibitor from Chan Seeds (Hyptis Suaveolens L.) Inhibits Proteases from the Larger Grain Borer Prostephanus Truncatus (Coleoptera: Bostrichidae). Comp. Biochem. Physiol. B Biochem. Mol. Biol. 2004, 138, 81–89. [Google Scholar] [CrossRef]
- Swathi, M.; Lokya, V.; Swaroop, V.; Mallikarjuna, N.; Kannan, M.; Dutta-Gupta, A.; Padmasree, K. Structural and Functional Characterization of Proteinase Inhibitors from Seeds of Cajanus Cajan (Cv. ICP 7118). Plant Physiol. Biochem. 2014, 83, 77–87. [Google Scholar] [CrossRef] [PubMed]
- Dantzger, M.; Vasconcelos, I.M.; Scorsato, V.; Aparicio, R.; Marangoni, S.; Macedo, M.L.R. Bowman-Birk Proteinase Inhibitor from Clitoria Fairchildiana Seeds: Isolation, Biochemical Properties and Insecticidal Potential. Phytochemistry 2015, 118, 224–235. [Google Scholar] [CrossRef] [PubMed]
- Mohanraj, S.S.; Tetali, S.D.; Mallikarjuna, N.; Dutta-Gupta, A.; Padmasree, K. Biochemical Properties of a Bacterially-Expressed Bowman-Birk Inhibitor from Rhynchosia Sublobata (Schumach.) Meikle Seeds and Its Activity against Gut Proteases of Achaea Janata. Phytochemistry 2018, 151, 78–90. [Google Scholar] [CrossRef] [PubMed]
- Martins, T.F.; Vasconcelos, I.M.; Silva, R.G.G.; Silva, F.D.A.; Souza, P.F.N.; Varela, A.L.N.; Albuquerque, L.M.; Oliveira, J.T.A. A Bowman-Birk Inhibitor from the Seeds of Luetzelburgia Auriculata Inhibits Staphylococcus Aureus Growth by Promoting Severe Cell Membrane Damage. J. Nat. Prod. 2018, 81, 1497–1507. [Google Scholar] [CrossRef] [PubMed]
- Lazza, C.; Trejo, S.; Obregon, W.; Pistaccio, L.; Caffini, N.; Lopez, L. A Novel Trypsin and α-Chymotrypsin Inhibitor from Maclura Pomifera Seeds. Lett. Drug Des. Discov. 2010, 7, 244–249. [Google Scholar] [CrossRef]
- Woloshuk, C.P.; Meulenhoff, J.S.; Sela-Buurlage, M.; Van Den Elzen, P.J.M.; Cornelissen, B.J.C. Pathogen-Induced Proteins with Inhibitory Activity toward Phytophthora Infestans. Plant Cell 1991, 3, 619–628. [Google Scholar] [CrossRef] [PubMed]
- Dokka, M.K.; Davuluri, S.P. Antimicrobial Activity of a Trypsin Inhibitor from the Seeds of Abelmoschus Moschatus L. Int. J. Curr. Microbiol. Appl. Sci. 2014, 3, 184–199. [Google Scholar]
- Mohammed, L.; Jha, G.; Malasevskaia, I.; Goud, H.K.; Hassan, A. The Interplay Between Sugar and Yeast Infections: Do Diabetics Have a Greater Predisposition to Develop Oral and Vulvovaginal Candidiasis? Cureus 2021, 13. [Google Scholar] [CrossRef] [PubMed]
- Rodrigues, C.F.; Rodrigues, M.E.; Henriques, M. Candida Sp. Infections in Patients with Diabetes Mellitus. J. Clin. Med. 2019, 8, 76. [Google Scholar] [CrossRef]
- Jaiswal, N.; Bhatia, V.; Srivastava, S.P.; Srivastava, A.K.; Tamrakar, A.K. Antidiabetic Effect of Eclipta Alba Associated with the Inhibition of Alpha-Glucosidase and Aldose Reductase. Nat. Prod. Res. 2012, 26, 2363–2367. [Google Scholar] [CrossRef]
- Konrad, B.; Anna, D.; Marek, S.; Marta, P.; Aleksandra, Z.; Józefa, C. The Evaluation of Dipeptidyl Peptidase (DPP)-IV, α-Glucosidase and Angiotensin Converting Enzyme (ACE) Inhibitory Activities of Whey Proteins Hydrolyzed with Serine Protease Isolated from Asian Pumpkin (Cucurbita Ficifolia). Int. J. Pept. Res. Ther. 2014, 20, 483–491. [Google Scholar] [CrossRef] [PubMed]
- Wang, R.; Zhao, H.; Pan, X.; Orfila, C.; Lu, W.; Ma, Y. Preparation of Bioactive Peptides with Antidiabetic, Antihypertensive, and Antioxidant Activities and Identification of α-Glucosidase Inhibitory Peptides from Soy Protein. Food Sci. Nutr. 2019, 7, 1848–1856. [Google Scholar] [CrossRef] [PubMed]
- Matsui, T.; Oki, T.; Osajima, Y. Isolation and Identification of Peptidic α-Glucosidase Inhibitors Derived from Sardine Muscle Hydrolyzate. Z. Für Naturforsch. Sect. C J. Biosci. 1999, 54, 259–263. [Google Scholar] [CrossRef]
- Yu, Z.; Yin, Y.; Zhao, W.; Yu, Y.; Liu, B.; Liu, J.; Chen, F. Novel Peptides Derived from Egg White Protein Inhibiting Alpha-Glucosidase. Food Chem. 2011, 129, 1376–1382. [Google Scholar] [CrossRef]
- Covaleda-Cortés, G.; Hernández, M.; Trejo, S.A.; Mansur, M.; Rodríguez-Calado, S.; García-Pardo, J.; Lorenzo, J.; Vendrell, J.; Chávez, M.A.; Alonso-del-Rivero, M.; et al. Characterization, recombinant production and structure-function analysis of NvCI, A picomolar metallocarboxypeptidase inhibitor from the marine snail nerita versicolor. Mar. Drugs 2019, 17, 511. [Google Scholar] [CrossRef] [PubMed]
- Maculins, T.; Garcia-Pardo, J.; Skenderovic, A.; Gebel, J.; Putyrski, M.; Vorobyov, A.; Busse, P.; Varga, G.; Kuzikov, M.; Zaliani, A.; et al. Discovery of protein-protein interaction inhibitors by integrating protein engineering and chemical screening platforms. Cell Chem. Biol. 2020, 27, 1441–1451. [Google Scholar] [CrossRef]

| Purification Step | Total Protein Amount (mg) | Total Inhibitory Activity (TIU) a | Specific Inhibitory Activity (TIU/mg) | Purity (Fold) b | Yield (%) c |
|---|---|---|---|---|---|
| Crude extract | 80.24 ± 0.17 | 44 ± 0.05 | 0.55 ± 0.01 | 1 | 100 |
| 100 eat treatment | 35.53 ± 0.06 | 39.4 ± 0.05 | 1.11 ± 0.01 | 2.1 | 89.5 |
| Affinity chromatography | 0.48 ± 0.02 | 37.1 ± 0.03 | 77.29 ± 0.06 | 140.5 | 84.3 |
Disclaimer/Publisher’s Note: The statements, opinions and data contained in all publications are solely those of the individual author(s) and contributor(s) and not of MDPI and/or the editor(s). MDPI and/or the editor(s) disclaim responsibility for any injury to people or property resulting from any ideas, methods, instructions or products referred to in the content. |
© 2023 by the authors. Licensee MDPI, Basel, Switzerland. This article is an open access article distributed under the terms and conditions of the Creative Commons Attribution (CC BY) license (https://creativecommons.org/licenses/by/4.0/).
Share and Cite
Cotabarren, J.; Ozón, B.; Claver, S.; Geier, F.; Rossotti, M.; Garcia-Pardo, J.; Obregón, W.D. A Multifunctional Trypsin Protease Inhibitor from Yellow Bell Pepper Seeds: Uncovering Its Dual Antifungal and Hypoglycemic Properties. Pharmaceutics 2023, 15, 781. https://doi.org/10.3390/pharmaceutics15030781
Cotabarren J, Ozón B, Claver S, Geier F, Rossotti M, Garcia-Pardo J, Obregón WD. A Multifunctional Trypsin Protease Inhibitor from Yellow Bell Pepper Seeds: Uncovering Its Dual Antifungal and Hypoglycemic Properties. Pharmaceutics. 2023; 15(3):781. https://doi.org/10.3390/pharmaceutics15030781
Chicago/Turabian StyleCotabarren, Juliana, Brenda Ozón, Santiago Claver, Florencia Geier, Martina Rossotti, Javier Garcia-Pardo, and Walter David Obregón. 2023. "A Multifunctional Trypsin Protease Inhibitor from Yellow Bell Pepper Seeds: Uncovering Its Dual Antifungal and Hypoglycemic Properties" Pharmaceutics 15, no. 3: 781. https://doi.org/10.3390/pharmaceutics15030781
APA StyleCotabarren, J., Ozón, B., Claver, S., Geier, F., Rossotti, M., Garcia-Pardo, J., & Obregón, W. D. (2023). A Multifunctional Trypsin Protease Inhibitor from Yellow Bell Pepper Seeds: Uncovering Its Dual Antifungal and Hypoglycemic Properties. Pharmaceutics, 15(3), 781. https://doi.org/10.3390/pharmaceutics15030781

